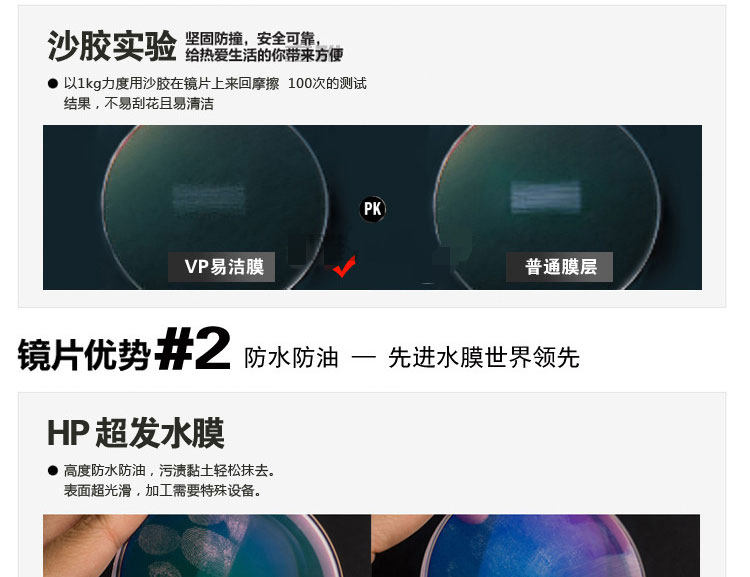

- Таобао
- Аксессуары
- Оптика
- Очки
- 39911686783
Hoya Lingya Lens y ' см. Отличный 1,50 Сферическая супер волосная вода HP Coter 1,56 1,60 стаканы

Цена: 951-14 287руб. (¥45)
Артикул: 39911686783
Вес товара: ~0.7 кг. Указан усредненный вес, который может отличаться от фактического. Не включен в цену, оплачивается при получении.
Описание товараPHA+PHA+PGltZyBhbGlnbj0iYWJzbWlkZGxlIiBzcmM9Imh0dHBzOi8vaW1nLmFsaWNkbi5jb20vaW1nZXh0cmEvaTMvMTY0NDUzMTU1NS9UQjJURE5KYjM5Si5lQmpTc3BwWFhYQUFWWGFfISExNjQ0NTMxNTU1LmpwZyI+PGltZyBhbGlnbj0iYWJzbWlkZGxlIiBzcmM9Imh0dHBzOi8vaW1nLmFsaWNkbi5jb20vaW1nZXh0cmEvaTMvMTY0NDUzMTU1NS9UQjJtcFhBYjRhSi5lQmpTc3ppWFhhSl9YWGFfISExNjQ0NTMxNTU1LmpwZyI+PGltZyBhbGlnbj0iYWJzbWlkZGxlIiBzcmM9Imh0dHBzOi8vaW1nLmFsaWNkbi5jb20vaW1nZXh0cmEvaTEvMTY0NDUzMTU1NS9UQjJlYVVaY21pSy5lQmpTWkZzWFhieFpwWGFfISExNjQ0NTMxNTU1LmpwZyI+PGltZyBhbGlnbj0iYWJzbWlkZGxlIiBzcmM9Imh0dHBzOi8vaW1nLmFsaWNkbi5jb20vaW1nZXh0cmEvaTIvMTY0NDUzMTU1NS9UQjJveTNaY2s1TS5lQmpTWkZyWFhYUGdWWGFfISExNjQ0NTMxNTU1LmpwZyI+PGltZyBhbGlnbj0iYWJzbWlkZGxlIiBzcmM9Imh0dHBzOi8vaW1nLmFsaWNkbi5jb20vaW1nZXh0cmEvaTQvMTY0NDUzMTU1NS9UQjJFM1pXY2sxTS5lQmpTWlBpWFhhd2ZwWGFfISExNjQ0NTMxNTU1LmpwZyI+PGltZyBhbGlnbj0iYWJzbWlkZGxlIiBzcmM9Imh0dHBzOi8vaW1nLmFsaWNkbi5jb20vaW1nZXh0cmEvaTMvMTY0NDUzMTU1NS9UQjJ0TUEzY2hxSy5lQmpTWkppWFhhT1NGWGFfISExNjQ0NTMxNTU1LmpwZyI+PGltZyBhbGlnbj0iYWJzbWlkZGxlIiBzcmM9Imh0dHBzOi8vaW1nLmFsaWNkbi5jb20vaW1nZXh0cmEvaTMvMTY0NDUzMTU1NS9UQjI2N0ZRYU5SemMxRmpTWkZQWFhjR0FGWGFfISExNjQ0NTMxNTU1LmpwZyI+PGltZyBzcmM9Imh0dHBzOi8vaW1nLmFsaWNkbi5jb20vaW1nZXh0cmEvaTMvMTY0NDUzMTU1NS9UMnZlU2tYaUJjWFhYWFhYWFhfISExNjQ0NTMxNTU1LmpwZyI+PC9wPjxkaXYgc3R5bGU9ImZvbnQtc2l6ZTogMC4wcHg7Ij7QmtC+0LQg0LfQsNGJ0LjRgtGLINGI0LDQsdC70L7QvdC+0LI8L2Rpdj48ZGl2IHN0eWxlPSJmb250LXNpemU6IDAuMHB4OyI+0JrQvtC0INC30LDRidC40YLRiyDRiNCw0LHQu9C+0L3QvtCyPC9kaXY+PHNwYW4gc3R5bGU9ImNvbG9yOiB3aGl0ZTtsaW5lLWZvbnQtc2l6ZTogMC4wcHg7Ij4tfC1fLXwtPC9zcGFuPjwvcD4=
Продавец:高端镜片批发直销
Рейтинг:

Всего отзывов:0
Положительных:0
Выберите вариацию / цвет
- HP Super Hair Pilm Room
- Ustellar/серая или чайная комната
- Выдающийся/смена серого или чая кликов
- HP Super Hair Film
Выберите размер / комплектацию
- 1.49 (обычный)
- 1,61 (тонкий)
- 1,56 (тонкий)
Добавить в корзину
- Информация о товаре
- Фотографии
| Показатель преломления линзы: | 1.49 (обычный), 1,56 (тонкий), 1,61 (тонкий) |
| Цвет: | HP Super Hair Film, HP Super Hair Pilm Room, Выдающийся/смена серого или чая кликов, Ustellar/серая или чайная комната |
| Липер подходящая степень: | В пределах 400 градусов, 400 градусов -650 градусов, 650 градусов -850 градусов, Выше 850 градусов |

Код защиты шаблонов
Код защиты шаблонов
-|-_-|-









